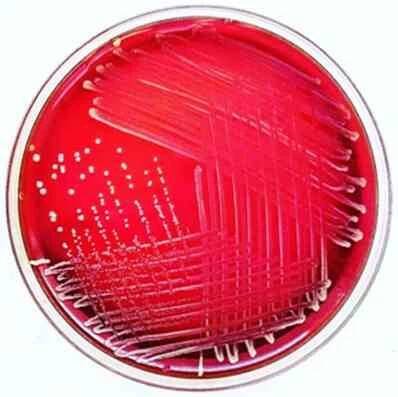
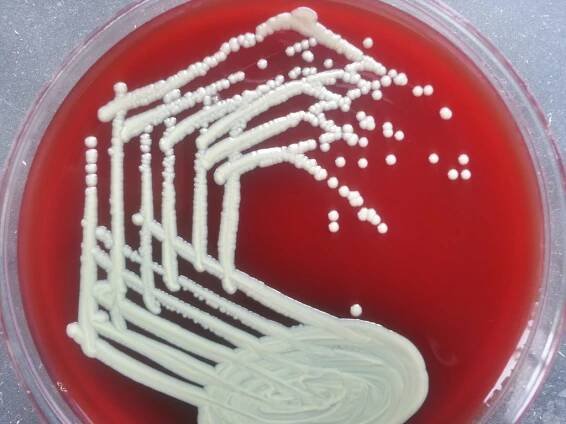
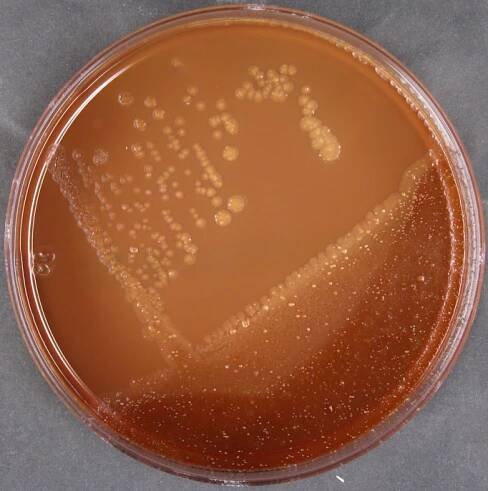

Corynebacterium diphtheriae
Bakterie

Corynebacterium diphtheriae je grampozitivní nepohyblivá fakultativně anaerobní bakterie bez pouzdra. Způsobuje onemocnění zvané záškrt, které se přenáší vzduchem. Nejčastěji vstupuje přes mandle a způsobuje těžkou angínu s pseudomembránami a možnými komplikacemi (horečka, myokarditis, laryngospasmus). Wikipedia
Lidé také hledají
Corynebacterium diphtheriae – Wikipedie
Corynebacterium diphtheriae je grampozitivní nepohyblivá fakultativně anaerobní bakterie bez pouzdra. Způsobuje onemocnění zvané záškrt, které se přenáší vzduchem.
Corynebacterium diphtheriae - Wikipedia
Corynebacterium diphtheriae [a ] is a Gram-positive pathogenic bacterium that causes diphtheria. [2 ] It is also known as the Klebs–Löffler bacillus because it was discovered in 1884 by German bacteriologists Edwin Klebs (1834–1913) and…
Corynebacterium diphtheriae | bacterium | Britannica
Other articles where Corynebacterium diphtheriae is discussed: diphtheria: …disease caused by the bacillus Corynebacterium diphtheriae and characterized by a primary lesion, usually in the upper respiratory tract, and more generalized…
Více než 30 stock fotografií, snímků a obrázků bez autorských…
Vyhledávejte z Corynebacterium Diphtheriae stock fotek, snímků a obrázků bez autorských poplatků od služby iStock. Vyhledejte zde vysoce kvalitní stock fotky, které jinde nenajdete.
Corynebacterium diphtheriae – WikiSkripta
Internetové studijní materiály pro studenty českých a slovenských lékařských fakult.
Corynebacterium diphtheriae – Zdravotní ústav se sídlem v…
Vyšetření > Diagnostika bakteriálních nákaz > Sérologická a molekulárně biologická vyšetření > Corynebacterium diphtheriae
Medvik: Corynebacterium diphtheriae
Je původcem diftérie, která má více klinických forem. Podle vzhledu kolonií rozlišujeme tři typy: gravis, mitis a intermedius.
Corynebacterium diphtheriae :: Biolife
Corynebacterium je rod bakterií, které jsou v přírodě široce rozšířené v mikrobiotě živočichů. Toxin produkující C. diphtheriae infikuje dýchací cesty a způsobuje především záškrt.
Corynebacterium Diphtheriae - Nabila Benamrouche - knihobot.cz
Corynebacterium diphtheriae ist der Erreger der Diphtherie, einer schweren, aber durch Impfung vermeidbaren Krankheit. Die Symptome reichen von leichter Angina bis zum Erstickungstod.
Difterie (záškrt) způsobená kmenem Corynebacterium diphtheriae…
Lékaři by měli být informováni o nutnosti zvážit záškrt v diferenciální diagnostice pacientů s kompatibilním klinickým obrazem.
odkazuje na služby nejen od Seznam.cz.
© 1996–2025 Seznam.cz, a.s.